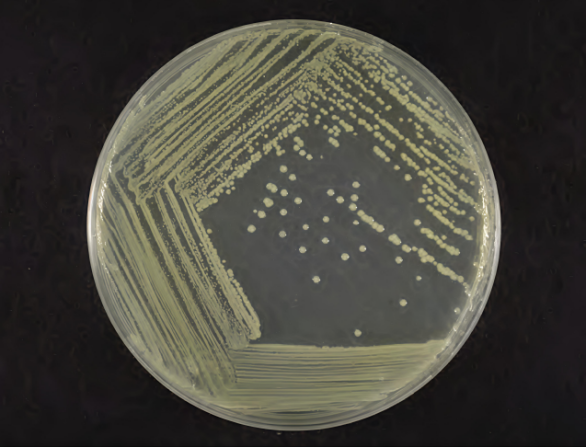
IMG_20250716_170240

1.琼氏不动杆菌(Acinetobacter junii)
物种名:琼氏不动杆菌
拉丁学名:Acinetobacter junii
分类学地位:细菌界Bacteria;变形菌门Proteobacteria;
γ-变形菌纲Gammaproteobacteria;假单胞菌目Pseudomonadales;
莫拉菌科Moraxellaceae;不动杆菌属Acinetobacter
琼氏不动杆菌(Acinetobacter junii)属于非发酵菌中不动杆菌属的重要病原细菌,可定植于机体的鼻、咽、皮肤等湿润部位,在机体免疫抑制受损、大量广谱抗生素应用时,可成为重要的机会感染病原菌。
1.1生物学特性
1.1.1培养特征
该菌可在37℃正常生长,在普通营养琼脂平板上的菌落圆形光滑、边缘整齐、稍隆起、浅灰白色、不透明;培养24 h直径多在1.5 mm左右;培养48 h的菌落直径多在1.8 mm左右。在血液营养琼脂上的与在普通营养琼脂上的相同。在普通营养肉汤中呈均匀混浊生长有点状菌体沉淀(摇动呈线状上升易消散),形成轻度菌膜(摇动易消散)[1]。菌株在TSA培养基上的菌落形态为浅黄色圆形、表面湿润、不透明、边缘整齐[2]。
图1 琼氏不动杆菌在TSA培养基上的菌落形态[2]
1.1.2形态学特征
琼氏不动杆菌为革兰氏染色阴性、无芽孢、两端钝圆,在28℃培养18 h后大小多为(0.5-1.0) μm×(0.8-1.4) μm的短杆状及球状细菌;37℃培养18 h的多数菌体的形态特征与28℃培养的基本一致,但表现稍大些,多在(0.6-1.0) μm×(1.0-1.8) μm,同时出现有较肥大个体、长丝状、蚯蚓状或粗细不均的长丝体、一端较膨大的长丝体等异常形态的菌体[1]。

图2 琼氏不动杆菌革兰氏染色镜检图
A:革兰氏染色照片[2],B:扫描电镜照片[3]
1.1.3生化特征
该菌在含0%和1% NaCl的环境中能生长,但在6% NaCl环境中不能生长。在酶类试验中,接触酶、卵磷脂酶试验呈阳性,氧化酶、DNA酶、淀粉酶、蛋白酶、乙酰胺酶、β-半乳糖苷酶、苯丙氨酸脱氨酶试验均为阴性;能利用吐温80。在代谢及化学物质利用方面,可利用Simmons枸橼酸盐、丙二酸盐和醋酸盐,不利用甘油、葡萄糖(既不产酸也不产气)、蔗糖、阿拉伯糖、甘露醇、鼠李糖、肌醇、山梨糖、蜜二糖、棉子糖、菊糖、水杨苷、七叶苷、麦芽糖、木糖、纤维二糖、果糖、苦杏仁苷、半乳糖、侧金盏花醇、海藻糖、甘露糖、卫茅醇、α-甲基-D-葡糖苷、乳糖。在其他理化试验中,O-F试验、产H₂S试验、动力(半固体)试验、明胶液化试验、硝酸盐还原试验、吲哚试验、甲基红试验、V-P试验、IPA试验均为阴性;对O/129(10 μg和150 μg)均有抗性[1]。
1.2分布、传播与致病性
1.2.1分布与传播
目前,琼氏不动杆菌已扩散至多个大洲,涉及15个国家。该菌广泛存在于多种生境中,包括饮用水、禽类养殖场以及新生儿的肠道等,并可能在人类、其他宿主以及环境之间实现相互传播[4, 5]。
1.2.2致病性
琼氏不动杆菌具有高效的异养硝化作用和需氧反硝化能力,可定植于机体的鼻、咽、皮肤等湿润部位,在一定条件下导致相应器官或系统的感染。琼氏不动杆菌感染以血流感染最为多见,也有研究发现其可导致脓胸、腹膜炎、角膜炎。中枢神经系统也是其靶器官之一,恶性血液病患者反复化学治疗会改变机体血脑屏障通透性,使琼氏不动杆菌等致病菌进入中枢神经系统而引起颅内感染[6]。
不动杆菌的致病机制包括对宿主细胞的粘附侵袭、形成生物膜,及对多种临床抗生素药物耐受等,这也是导致院内继发感染的重要原因[7]。
1.3检测方法
(1)传统方法:依赖于对菌株形态学特征的观察,以及对其生理生化特性的系统检测与分析,进而进行综合鉴定。
(2)分子生物学方法:根据毛芝娟等[7]研究,琼氏不动杆菌的分子鉴定需结合16S rRNA初筛与rpoB基因确认。流程如下:取菌液经离心、洗涤,用TZ缓冲液处理得基因组DNA;用通用引物P1/P2扩增16S rRNA基因(约1500 bp),两对特异性引物P3/P4、P5/P6扩增rpoB基因(各约2000 bp),经特定PCR程序;产物测序后拼接,比对并构建系统发育树完成鉴定。
表1 琼氏不动杆菌引物序列
| 基因 | 引物名称 | 引物序列 |
| 16S rRNA | P1 | 5′-AGAGTTTGATCCTGGCTCAG-3′ |
| P2 | 5′-GGTACCTTGTTACGACTT-3′ | |
| rpoB | P3 | 5′-ATGCATTACCATAATACCGAAA-3′ |
| P4 | 5′-GGTTTCTCAGCACGAAGTCTAG-3′ | |
| P5 | 5′-AGGCTCTTCTTACACTTCTT-3′ | |
| P6 | 5′-AGTCACCATTTTTCAGTTCA-3′ |
1.4典型案例
1994年6月至9月,德国弗莱堡大学医院儿科肿瘤科的3名儿童先后发生4次由琼氏不动杆菌引起的菌血症,经广谱抗生素治疗后迅速好转。环境采样发现,病房供水系统被该菌污染,分子分型显示存在两种菌株,引发感染的菌株(A型)仅存在于工作人员房间的水龙头中,且水龙头曝气器污染情况较去除曝气器后的水样更严重,推测曝气器作为细菌储存库,通过手接触等方式导致患者感染[8]。
1.5防治对策
养殖实践中必须提高警惕,对进水水源严加控制,不从受污染水体进水;设立蓄水池,进水需先进行沉淀、消毒后方能使用,从源头上控制病原的进入,才能有效预防感染的发生。而多耐药性不动杆菌对养殖鱼类的感染不仅危害养殖业本身,同时,也可能导致人类的食源性感染[7]。
参考文献
[1] 陈翠珍, 张晓君, 房海 等. 锦鲤中琼氏不动杆菌的分离与鉴定. 水生态学杂志, 2009, 2: 86-90.
[2] 刘三, 田会会, 钟启平. 一株琼氏不动杆菌的分离鉴定及固态发酵制备的研究. 工业微生物, 2025, 55: 13-15.
[3] 胡琼, 唐洁, 雷丹 等. 一株溴氰菊酯降解菌的分离鉴定及其降解条件优化. 微生物学通报, 2020, 47: 699-709.
[4] 汤荣, 陈雯静, 易峻文 等. 琼氏不动杆菌和鲁氏不动杆菌的临床分布及耐药分析. 上海交通大学学报 (医学版) , 2017, 37: 386-389.
[5] Aguilar-Vera A, Bello-López E, Pantoja-Nuñez GI et al. Acinetobacter junii: an emerging One Health pathogen. mSphere. 2024, 9: e0016224.
[6] 孙雷, 章卫平, 陈洁 等. 脑脊液高通量基因测序诊断造血干细胞移植术后颅内琼氏不动杆菌感染1例报告. 海军军医大学学报, 2023, 44: 378-381.
[7] 毛芝娟, 毛甬州, 汪建萍. 两株鱼源琼氏不动杆菌的分离、鉴定和耐药特性分析. 水产学报, 2013, 37: 1572-1578.
[8] Kappstein I, Grundmann H, Hauer T et al. Aerators as a reservoir of Acinetobacter junii: an outbreak of bacteraemia in paediatric oncology patients. Journal of Hospital Infection, 2000, 44: 27-30.
.png)
